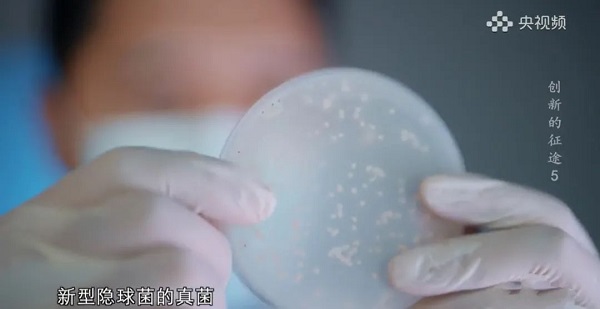
4.jpg

这么厉害啊,买少了,明天冲高后也加仓!
◆
◆
发表于 2025-11-03 10:25:00
发布于 安徽
$N丹娜(SZ920009)$ $C禾元-U(SH688765)$
8月14日晚,中央广播电视总台纪录频道(CCTV-9)重磅纪录片《创新的征途》第五集《守护生命》,将镜头对准了与死神赛跑的"生命工程师"。丹娜生物作为中国侵袭性真菌病早期诊断技术的领跑者,创新成果通过央视荧幕生动展现。
“在滨海新区,创新不是选择题,而是必答题”——这句《创新的征途》纪录片中的旁白,恰是丹娜生物科技征程的注脚。当镜头扫过实验室里闪烁的检测仪,画外音掷地有声:“1小时,是生命与死亡的新分界线”。侵袭性真菌病是一种严重的感染类型疾病,具有“三高一难”的特点,即高发病率、高漏诊率、高死亡率、诊断困难,每年全球超过500万人受该病的死亡威胁,“快速检测成为了治疗真菌感染的关键所在”!
丹娜生物创新团队“十年如一日”,聚焦侵袭性真菌病精准诊断技术,先后开发了一系列创新诊断产品,全球率先提出真菌病“5G+”早期快速联合诊断方案。尤其在分子诊断方面,丹娜生物采用创新专利技术,解决了样本前处理中真菌破壁的难题, 将真菌诊断带入“小时级精准时代”,彰显了强劲的全球市场竞争力。正如总导演在花絮中强调:“这些创新者,正在用分子语言重写生命密码”,“无数生命被重新点燃”。

郑重声明:用户在财富号/股吧/博客等社区发表的所有信息(包括但不限于文字、视频、音频、数据及图表)仅代表个人观点,与本网站立场无关,不对您构成任何投资建议,据此操作风险自担。请勿相信代客理财、免费荐股和炒股培训等宣传内容,远离非法证券活动。请勿添加发言用户的手机号码、公众号、微博、微信及QQ等信息,谨防上当受骗!
评论该主题
帖子不见了!怎么办?作者:您目前是匿名发表 登录 | 5秒注册 作者:,欢迎留言 退出发表新主题
温馨提示: 1.根据《证券法》规定,禁止编造、传播虚假信息或者误导性信息,扰乱证券市场;2.用户在本社区发表的所有资料、言论等仅代表个人观点,与本网站立场无关,不对您构成任何投资建议。用户应基于自己的独立判断,自行决定证券投资并承担相应风险。《东方财富社区管理规定》

